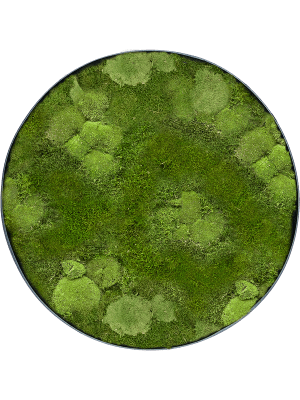

Mosschilderij Bolmos en Platmos - Antraciet frame - 100 cm
| Pot diepte: 5 |
| Pot diameter: 100 |
Je dynamische Snippet wordt hier weergegeven...
Dit bericht wordt weergegeven omdat je niet zowel een filter als een sjabloon hebt opgegeven om te gebruiken.
Bezoek onze showroom in Oostrum (Venray)
Met eigen ogen zien hoe realistisch onze kunstplanten zijn? Je bent van harte welkom om te komen kijken in onze showroom. Hier alle info over openingstijden en bereikbaarheid.